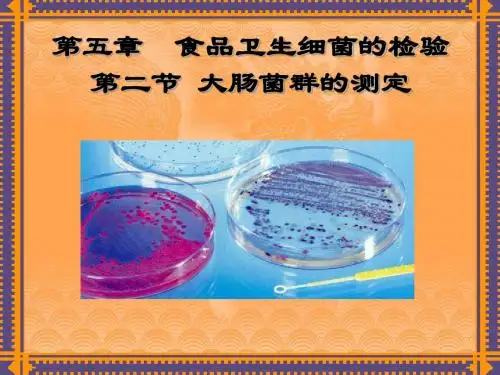

食品中大肠菌群的测定资料讲解
- 格式:ppt
- 大小:415.00 KB
- 文档页数:8


食品中大肠菌群的测定实验报告实验报告:食品中大肠菌群的测定实验目的:本次实验旨在从食品样品中测定大肠菌群的数量,评估食品质量。
实验材料和设备:1.食品样品:选取自超市购买的鸡胸肉、蔬菜和熟食。
2.蒸馏水:用于洗涤器皿和稀释。
3.无菌平板:用于接种样品。
4.无菌移液枪和滴管:用于转移样品。
5.培养箱:用于培养菌落。
6.细菌计数器:用于计数菌落。
实验步骤:1.用酒精灯消毒操作台、无菌平板和蒸馏水瓶等器皿和仪器。
2.将样品洗净,切成小块,加入100ml蒸馏水中,进行融解和均匀混合。
3.将每份样品分别进行10倍、100倍和1000倍的稀释,每次稀释前,用无菌移液枪取20μl的样品,转移到10ml蒸馏水中。
4.在无菌平板上接种100μl、1ml和10ml,封口后分别进行孵育。
5.在恰当温度下孵育48小时后,观察平板上菌落的数量,并使用细菌计数器进行计数。
6.根据每份样品最接近的平板菌落数量计算其大肠菌群的数量。
并按照汉生、美国食品和药物管理局的相关标准得出评估结论。
实验结论:食品样品大肠菌群的测定结果如下:鸡胸肉:大肠菌群数量为2.1×10³ CFU/g,未达到汉生标准(≤1×10⁵ CFU/g),但超过了FDA标准(≤1×10³ CFU/g)。
蔬菜:大肠菌群数量为3.5×10³ CFU/g,也未达到汉生标准,但符合FDA标准。
熟食:大肠菌群数量为4.8×10³ CFU/g,达到了汉生标准但未达到FDA标准。
综上所述,鸡胸肉和熟食存在较高的大肠菌群数量,不健康,蔬菜样品数量较为合规。
建议消费者购买高品质、优良质检合格的食品,注意食品安全与健康。


一、实验目的1. 了解大肠菌群在食品卫生检验中的意义。
2. 学习并掌握大肠菌群的检验原理和方法。
3. 通过实验判别食品的卫生质量。
二、实验原理大肠菌群是一群能在37℃经24小时发酵乳糖、产酸产气、需氧和兼性厌氧的革兰氏阴性无芽孢杆菌。
该菌群主要来源于人畜粪便,因此常被用作粪便污染指标,以评价食品的卫生质量。
大肠菌群的存在反映了食品是否被粪便污染,同时也间接指出食品中是否有肠道致病菌污染的可能性。
食品中大肠菌群数的测定采用最近似数法。
该方法通过将样品多次稀释至无菌,然后接种于培养基中,经培养后根据结果查阅MPN检索表,得到原样品中微生物的估计数量。
三、实验材料1. 样品:乳、肉、禽蛋制品、饮料、糕点、发酵调味品或其他食品。
2. 菌种:大肠埃希氏菌产气肠杆菌。
3. 培养基及试剂:单料乳糖胆盐发酵管、双料乳糖胆盐发酵管、乳糖胆盐发酵管、伊红美蓝琼脂、革兰氏染色液、蛋白陈水、靛基质试剂、麦康凯(MA)。
4. 其他设备和材料:高压湿热灭菌器、显微镜、载玻片、灭菌培养皿、灭菌吸管、试管、三角瓶、接种环、恒温培养箱等。
四、实验步骤1. 样品预处理:取适量样品,加入适量无菌生理盐水,进行均质处理。
2. 稀释:将均质后的样品进行系列稀释,稀释度可根据样品污染程度进行调整。
3. 接种:将稀释后的样品接种于乳糖胆盐发酵管中,每支试管接种3-5ml。
4. 培养:将接种后的发酵管置于37℃恒温培养箱中培养24小时。
5. 检查:观察发酵管内是否有气泡产生,如有气泡产生,则说明样品中含有大肠菌群。
6. 计数:根据发酵管内气泡产生的情况,计算出样品中大肠菌群的近似数量。
7. 验证:对疑似大肠菌群进行革兰氏染色和生化试验,以确定其是否为大肠菌群。
五、实验结果与分析1. 样品中大肠菌群数量:根据实验结果,样品中大肠菌群数量为每克样品含有1000个左右。
2. 验证结果:对疑似大肠菌群进行革兰氏染色和生化试验,结果显示为革兰氏阴性、无芽孢、呈杆状,符合大肠菌群的特性。

实验三十二食品中大肠菌群的测定1.目的要求(1)学习和掌握大肠菌群的测定方法。
(2)了解测定过程中每一步的反应原理。
2.基本原理大肠菌群是一群能在37。
C下培养48h发酵乳糖产酸、产气的需氧或兼氧革兰氏染色阴性无芽孢杆菌。
以大肠杆菌为主,包括肠细菌属、柠檬酸细菌属、埃希氏菌属和克雷伯氏菌属等。
大肠菌群数可用来判断水源或食品被粪便污染的可能性和程度。
因为大肠菌群在肠道和粪便中数量非常高,且与肠道和粪便中的病原菌生活习性相近,抗逆能力稍强,在数量上两者具有一定相关性,且大肠菌群易于培养和检测,所以非常适合用来作为判断样品是否被人、畜粪便污染的标志。
大肠菌群的测定方法一般采用多管发酵法。
此法是根据大肠菌群具有发酵乳糖产酸、产气的特性,利用含乳糖的培养基培养不同稀释度的样品,经初发酵、平板分离和复发酵3个检测步骤,最后根据结果查最大自然数表,算出食品中的大肠菌群数。
3.器材(1)被检样品-根据不同需要选择被检样品,如自来水、酱油、食醋、酸乳、啤酒等。
(2)培养基:乳糖胆盐发酵培养基,伊红美蓝固体培养基,乳糖发酵培养基。
(3)试剂:革兰氏染色液,芽孢染色液。
(4)其他物品:显微镜,天平,培养箱,水浴锅,研钵,平皿,杠氏管,试管‘,刻度吸管,涂布器等。
4.操作步骤(1)初发酵实验。
在3倍浓缩乳糖培养基中加入稀释度为10~,10~,10。
的被检样品10mL(如大肠菌群超出检测限,则可取更高的稀释度),每个稀释度进行5次重复,混匀置于370C下培养24h。
(2)平板分离。
培养24h后如不产酸(乳糖发酵液变黄色)、产气(小指管底部有气泡)和不变浑浊者为阴性反应,产酸、产气或仅产酸的乳糖发酵管为阳性反应。
将阳性反应划线接种于伊红美蓝平板上,在370C下培养24h。
在伊红美蓝平板上大肠菌群的典型菌落为深紫黑色,具有金属光泽;或者紫黑色,不带或略带金属;或者淡紫红色,中心较深的菌落。
将带有上述典型特征的菌落做革兰氏染色镜检。

食品中大肠菌群的测定实验报告一、实验目的。
本实验旨在测定食品中的大肠菌群数量,以评估食品的卫生安全水平。
二、实验原理。
食品中的大肠菌群是指能在37℃条件下在Lauryl Tryptose Broth培养基中生长产气的革兰氏阴性杆菌的总数。
大肠杆菌是大肠菌群的代表性菌种,因此其数量可以作为食品卫生安全的指标之一。
三、实验步骤。
1. 取样,从不同来源的食品中取样,如肉类、蔬菜、水果、奶制品等。
2. 样品处理,将取样的食品样品进行处理,如洗涤、研磨等,以获得可检测的样品。
3. 菌落计数,将处理后的样品接种在Lauryl Tryptose Broth培养基中,培养一定时间后,进行菌落计数。
4. 数据分析,根据菌落计数结果,计算出食品中的大肠菌群数量。
四、实验结果。
经过实验测定,不同食品样品中的大肠菌群数量有所不同。
其中,肉类制品中的大肠菌群数量较高,蔬菜水果中次之,奶制品中较低。
这表明食品的卫生安全水平存在一定差异。
五、实验结论。
食品中的大肠菌群数量是评估食品卫生安全水平的重要指标之一。
通过本实验的测定,可以初步评估食品的卫生安全状况,为食品生产和消费提供参考依据。
未来可以结合其他指标和方法,进一步完善食品卫生安全评估体系。
六、实验注意事项。
1. 在取样和处理过程中,要注意避免外源污染,以保证实验结果的准确性。
2. 在菌落计数过程中,要严格按照操作规程进行,避免误差的产生。
3. 实验结束后,要及时清洗和消毒实验器材,以确保实验室的卫生安全。
七、参考文献。
1. 《食品微生物学实验指导》,XXX,XXX出版社,200X年。
2. 《食品卫生与安全》,XXX,XXX出版社,200X年。
以上为食品中大肠菌群的测定实验报告内容,谢谢阅读。

实验--食品中大肠菌群的测定-课件 (一)随着人们对食品安全的重视,食品中大肠菌群的测定越来越受到关注和重视。
在食品安全监测和生产中,常常需要进行大肠菌群的检验,以保证食品的卫生安全。
此次实验旨在学习并掌握食品中大肠菌群的测定方法。
实验一、菌落计数法1.准备样品:取适量的食品样品,如牛奶、肉制品等,加入适量的蒸馏水,充分摇匀后待用。
2.制备平板:准备好平板培养基,常用的有菌落总数计数培养基和大肠杆菌计数培养基等。
用已灭菌的棉签挖取少量培养基涂抹在培养皿上,使其均匀分布。
3.采样:用无菌的移液管取一定量的稀释后的样品,滴于培养皿表面。
4.培养:将培养皿倒置放入恒温箱中,在37℃温度下培养24-48小时。
5.计数:观察培养皿上的菌落数量,使用菌落计数器进行计数,按一定倍数(如1/10、1/100)还原为真实菌落数量。
实验二、MPN法1.制备移液器:准备好10个稀释液和10个带有3个具孔的板,每个孔中加入相应的稀释液。
2.取样:从食品样品中取一定量,用蒸馏水稀释后,分别分装到板中。
3.培养:将板放到37℃恒温培养箱中进行培养,观察是否有生长。
4.判断仪器读数:根据板中生长、未生长的情况计算菌落数,并用最可能数法计算出MPN结果。
总结通过两种方法的比较,可以看出,两种方法都有各自的优点和缺点,需要根据实际需求进行选择。
对于无法进行菌落计数的样品,可以选择MPN法,它具有精度高、结果稳定等特点。
而对于数量较少的样品,可以更为准确地使用菌落计数法。
本次实验学习了食品中大肠菌群的测定方法,虽然实验中用了人工计数,但实际工作中,常常会结合现代化设备进行自动化检测,从而提高检测效率和准确度。
对于保障食品卫生安全,这一方面的控制是很有必要的。

资料范本本资料为word版本,可以直接编辑和打印,感谢您的下载实验一食品中大肠菌群的测定地点:__________________时间:__________________说明:本资料适用于约定双方经过谈判,协商而共同承认,共同遵守的责任与义务,仅供参考,文档可直接下载或修改,不需要的部分可直接删除,使用时请详细阅读内容大肠菌群(M.R.N.)的测定一、实验目的:(1)了解大肠菌群在食品卫生检验中的意义(2)学习并掌握大肠菌群的检验原理和方法,以判别食品的卫生质量二、实验原理:大肠菌群系指一群能在37℃经24h能发酵乳糖,产酸产气,需氧和兼性厌氧的革兰氏阴性无芽孢杆菌。
该菌主要来源于人畜粪便,故以此作为粪便污染指标来评价食品的卫生质量,具有广泛的卫生学意义。
它反映了食品是否被粪便污染,同时间接地指出食品是否有肠道致病菌污染的可能性。
食品中大肠菌群数系以每100g(或ml)检样内大肠菌群最近似数(the most probable number-简称MPN)表示。
最近似数(most probable number-简称MPN)法是一种将样品“多次(管)稀释至无菌”的计数方法。
将3个稀释梯度的检样稀释液接种于9支或15支试管培养基中,每个稀释度接种3支或5支。
经培养后,根据结果查阅MPN检索表,就可得到原样品中微生物的估计数量。
MPN测定方法尤其适用于带菌量极少、其他方法不能检测的食品。
如水、乳制品及其他食品中大肠菌群的计数。
三、材料1、样品乳、肉、禽蛋制品、饮料、糕点、发酵调味品或其他食品。
2、菌种大肠埃希氏菌(Escherichia coli)产气肠杆菌(Enterobacteria aerogenes)3、培养基及试剂单料乳糖胆盐发酵管、双料乳糖胆盐发酵管、乳糖胆盐发酵管、伊红美蓝琼脂(EMB)、革兰氏染色液、蛋白陈水、靛基质试剂、麦康凯(MA)4、其它设备和材料温箱(36土1)℃、水浴锅(44土0.5)℃、天平、显微镜、均质器或乳钵、温度计、平皿、试管、发酵管、吸管、载玻片、接种针。


食品中大肠菌群的检验简介大肠菌群是指含有大肠菌属(Escherichia coli)和奇异变形杆菌属(Coliform bacteria)的细菌群体。
它们存在于人和动物的肠道中,也可以存在于环境中,如土壤、水体和食品中。
食品中的大肠菌群是导致食品中毒的主要病原体之一。
因此,对食品中大肠菌群的检验非常重要,以确保食品的卫生和安全。
本文将介绍食品中大肠菌群的检验方法和操作流程。
方法和步骤1. 样品采集样品采集是食品中大肠菌群检验的第一步。
根据需要检验的食品种类,选择合适的采样方法。
常见的食品样品包括水果、蔬菜、肉类和乳制品等。
采集样品时,应使用干净无菌的容器,并避免污染。
确保样品的代表性,避免极端状况下的取样,如选择已烂的水果或有明显变质的食品。
2. 样品处理样品处理是为了提取样品中的菌群以进行后续的检测。
处理过程应在无菌条件下进行,以避免外部的污染。
常见的样品处理方法包括:•加入盐水:将样品加入含有氯化钠的缓冲液中,以便菌群的释放。
•搅拌和均质:使用搅拌器或者均质器将样品搅拌均匀,以确保菌群的均匀分布。
•过滤:通过滤膜将样品过滤,以分离固体物质和悬浮物。
3. 培养基选择选择适当的培养基是进行大肠菌群检验的关键。
常用的培养基包括马铃薯葡萄糖琼脂(Plate Count Agar,PCA)、大肠杆菌选择琼脂(MacConkey Agar)、经典蓝琼脂(Eosin Methylene Blue Agar)等。
不同的培养基适用于不同目的的检验。
PCA适用于总菌群计数,MacConkey Agar适用于大肠菌群的选择性检测,Eosin Methylene Blue Agar适用于大肠杆菌的计数和鉴别。
4. 培养和孵育将样品处理后的培养基平板进行孵育。
孵育的时间和温度根据菌群的生长特性而定。
一般情况下,孵育时间为24小时,温度为37摄氏度。
培养过程中,需要注意避免交叉污染。
每个样品应使用独立的培养基平板进行孵育,且标记清楚以区分不同样品。
一、实验目的1. 了解大肠菌群在食品卫生检验中的意义。
2. 学习并掌握大肠菌群的检验原理和方法。
3. 通过实验,掌握食品卫生质量的判断标准。
二、实验原理大肠菌群是指一群能在37℃经24小时发酵乳糖、产酸产气、需氧和兼性厌氧的革兰氏阴性无芽孢杆菌。
该菌主要来源于人畜粪便,故以此作为粪便污染指标来评价食品的卫生质量,推断食品中是否有污染肠道致病菌的可能。
三、实验材料1. 样品:乳、肉、禽蛋制品、饮料、糕点、发酵调味品或其他食品。
2. 菌种:大肠埃希氏菌、产气肠杆菌。
3. 培养基及试剂:单料乳糖胆盐发酵管、双料乳糖胆盐发酵管、乳糖胆盐发酵管、伊红美蓝琼脂、革兰氏染色液、蛋白陈水、靛基质试剂、麦康凯(MA)。
4. 其他设备和材料:温箱、移液器、无菌试管、无菌吸管、无菌培养皿等。
四、实验方法1. 样品处理:取适量样品,加入适量的蛋白陈水,进行均质化处理。
2. 稀释:将均质化后的样品进行10倍梯度稀释,分别取不同稀释度的样品进行接种。
3. 接种:将稀释后的样品接种于乳糖胆盐发酵管中,每个稀释度接种3支试管。
4. 培养:将接种好的发酵管放入37℃恒温培养箱中培养24小时。
5. 观察结果:观察发酵管中的变化,如产生气泡、颜色变化等,判断大肠菌群的存在。
6. 鉴定:对疑似大肠菌群的菌落进行革兰氏染色、麦康凯培养基培养等鉴定。
五、实验结果与分析1. 发酵管观察结果:经过24小时培养,部分发酵管出现气泡、颜色变化等现象,表明存在大肠菌群。
2. 鉴定结果:对疑似大肠菌群的菌落进行革兰氏染色、麦康凯培养基培养,结果显示菌落呈革兰氏阴性、麦康凯培养基上呈现红色,确定为大肠菌群。
六、实验结论通过本次实验,我们掌握了食品中大肠菌群的检验原理和方法,成功检测出样品中存在大肠菌群。
这表明该食品可能存在粪便污染,存在食品安全隐患。
在实际生产过程中,应加强食品卫生管理,确保食品安全。
七、实验注意事项1. 实验操作过程中,注意无菌操作,防止污染。
食品微生物大肠菌群检测方法食品微生物大肠菌群检测是食品安全领域中的一项重要工作,其结果直接关系到食品的卫生安全。
在食品加工、储存和运输过程中,微生物大肠菌群的存在和数量是一个重要的指标,因此需要建立准确、可靠的检测方法来保障食品安全。
本文将介绍几种常用的食品微生物大肠菌群检测方法,以供参考。
一、传统培养法。
传统培养法是一种常用的微生物检测方法,其原理是将食品样品在适当的培养基上进行培养,然后通过计数菌落形成的数量来确定大肠菌群的存在和数量。
这种方法简单易行,成本低廉,但需要较长的培养周期,且存在一定的误差。
因此,在实际应用中,需要结合其他方法进行验证。
二、分子生物学方法。
分子生物学方法是近年来发展起来的一种食品微生物检测方法,其原理是利用PCR、实时荧光定量PCR等技术,通过检测食品样品中的微生物DNA或RNA来确定大肠菌群的存在和数量。
这种方法具有高灵敏度、高特异性和快速的优点,能够准确地检测出微生物的存在和数量,但需要较为复杂的实验操作和设备。
三、免疫学方法。
免疫学方法是利用抗原与抗体之间的特异性反应来检测微生物的存在和数量。
常用的免疫学方法包括酶联免疫吸附法(ELISA)和免疫荧光法等。
这种方法具有高灵敏度、高特异性和快速的优点,但需要较为复杂的实验操作和设备,且对样品的预处理要求较高。
综上所述,食品微生物大肠菌群检测方法有多种,各有优缺点,需要根据实际情况选择合适的方法进行检测。
在实际应用中,可以结合多种方法进行验证,以确保检测结果的准确性和可靠性。
希望本文介绍的方法能够为食品安全领域的从业人员提供一定的参考价值。